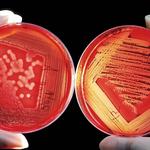

Bournemouth Anti-Wrinkle Experts
About Business
Discover the Best Botox in Bournemouth : Where Elegance Meets Expertise
In the charming coastal town of Bournemouth, amidst breathtaking landscapes and a vibrant atmosphere, lies a haven for those seeking the pinnacle of beauty and rejuvenation. Welcome to the realm of the "Best Botox in Bournemouth," an esteemed destination where elegance and expertise intertwine to offer unparalleled anti-aging solutions. With a commitment to natural-looking results and a reputation for excellence, this premier clinic is poised to redefine your perception of aesthetic enhancement.
A Name Synonymous with Perfection:
With an unrivaled reputation that precedes them, the "Best Botox in Bournemouth" has carved a niche as the go-to destination for those in pursuit of age-defying beauty. Under the guidance of esteemed medical professionals, this clinic has garnered a legion of loyal clients, each testament to the transformative power of their treatments.
Expert Medical Professionals:
At the heart of the "Best Botox in Bournemouth" is a team of expert medical professionals, meticulously chosen for their vast experience, unwavering dedication, and innate artistry. From board-certified dermatologists to skilled injectors, each member of this elite team possesses an innate understanding of facial anatomy, ensuring precise and harmonious results with every treatment.
Tailored Solutions:
Acknowledging that every individual is unique, the "Best Botox in Bournemouth" prides itself on offering bespoke solutions that cater to each client's distinct needs and desires. The team conducts thorough consultations, attentively listening to clients' aspirations and concerns, thus crafting personalized treatment plans designed to achieve optimal and natural-looking outcomes.
FDA-Approved Botox:
As a pillar of ethical practice, the "Best Botox in Bournemouth" exclusively utilizes FDA-approved Botox formulations, ensuring the utmost safety and efficacy in their treatments. Clients can rest assured that each injection is administered with the highest standard of care, adhering to rigorous medical protocols.
Unveiling Timeless Beauty:
The "Best Botox in Bournemouth" specializes in harnessing the power of Botox to diminish fine lines, wrinkles, and expression lines that often reveal the passage of time. By strategically relaxing facial muscles, their treatments offer a rejuvenated and refreshed appearance, restoring youthful allure without sacrificing natural expressions.
Pain-Free Experience:
Pampering their clients is a hallmark of the "Best Botox in Bournemouth," and this extends to the treatment process itself. Utilizing advanced techniques and the latest in pain-reduction methodologies, their skilled injectors ensure that the experience is gentle, comfortable, and virtually pain-free.
Embrace the Journey:
The "Best Botox in Bournemouth" believes that beauty is not an endpoint, but rather an ever-evolving journey. With this vision, they foster lasting relationships with clients, guiding them through the transformative process with grace and compassion. Their support extends beyond treatments, empowering individuals to embrace the natural beauty of every stage of life.
In the heart of Bournemouth, the "Best Botox in Bournemouth" beckons you to embark on an extraordinary voyage of timeless beauty. With a team of consummate professionals, an unwavering commitment to excellence, and a dedication to crafting personalized solutions, this esteemed clinic redefines the possibilities of aesthetic enhancement. If you seek a refined, natural, and graceful rejuvenation, look no further than the "Best Botox in Bournemouth." Embrace the journey to timeless allure and unlock the radiant version of yourself that awaits.
Unveiling the Lowest Botox costs in Bournemouth: A Budget-Friendly Path to Youthful Radiance
Nestled along the stunning South Coast, Bournemouth welcomes you with a delightful surprise - the most affordable Botox prices in town. Offering a golden opportunity to enhance your natural beauty without breaking the bank, this destination for budget-conscious individuals promises exceptional anti-aging solutions at unbeatable rates. Say hello to youthful radiance with confidence, as we explore the affordable world of Botox in Bournemouth.
Accessible Beauty for All:
At the heart of the most affordable Botox prices in Bournemouth lies a deep commitment to making beauty accessible to all. Understanding the desire for age-defying treatments without financial strain, this clinic sets the stage for inclusive rejuvenation, empowering clients from all walks of life to embrace their beauty aspirations.
Expert Medical Professionals:
Affordable does not mean compromising on quality or expertise. Bournemouth's budget-friendly Botox clinic boasts a team of seasoned medical professionals, renowned for their precision and artistry in administering Botox injections. Each practitioner upholds the highest standards of safety and care, ensuring optimal results for every client.
Transparent Pricing:
The most affordable Botox prices in Bournemouth are anchored in transparency. Clients can bid farewell to hidden fees and unexpected costs, as this clinic is dedicated to providing straightforward and clear pricing, making the journey to youthful allure a stress-free experience.
Customized Solutions:
One size does not fit all, and this clinic knows it best. Offering personalized consultations, their skilled practitioners attentively listen to clients' desires and concerns, tailoring Botox treatments to match individual facial contours and cosmetic goals. Clients can rest assured that they receive a treatment plan uniquely suited to their needs.
Quality Botox Products:
Affordability doesn't mean compromising on product quality. The most affordable Botox prices in Bournemouth embrace FDA-approved Botox products, ensuring both safety and effectiveness in each injection. Clients can confidently explore the benefits of this renowned anti-aging treatment without any compromise on quality.
A Warm and Welcoming Environment:
Beyond affordable prices, the clinic nurtures a warm and welcoming environment for clients to feel at ease throughout their rejuvenation journey. Their compassionate staff provides support and guidance, fostering a sense of belonging for those seeking to enhance their natural beauty.
Embrace Your Timeless Beauty:
The most affordable Botox prices in Bournemouth pave the way for individuals to embrace their timeless beauty. By effectively softening wrinkles and expression lines, these treatments reveal a refreshed and rejuvenated version of oneself. Say hello to a more confident and radiant you.
Bournemouth reveals its budget-friendly secret - the most affordable Botox prices in town. Here, the pursuit of youthful allure becomes a reality for all, with expert practitioners, transparent pricing, and a commitment to accessible beauty. If you've dreamed of enhancing your natural beauty without financial strain, the most affordable Botox prices in Bournemouth beckon you to take the plunge. Embrace your timeless radiance, and let this budget-friendly journey redefine the possibilities of aesthetic rejuvenation.
Now are you bothered by unwanted wrinkles? Botox might be the ideal solution for you! It's one of the most effective treatments available for addressing common wrinkles.Not sure if Botox is the right choice for you? Let's have a friendly chat to determine whether this treatment suits your needs. We are more than happy to offer a free phone consultation to answer any questions you may have.
If you're interested in Best Botox in Bournemouth, don't hesitate to reach out to us. We'd love to have a conversation with you. For your reference, here are our Botox prices in Bournemouth:
For more details about our Botox in Bournemouth, you can also visit our Google page.
Other Businesses

Barbers
The Gentry Men's Salon & Upscale Barbershop

Hair Salons
Hair and Lashes by Lisa

Barbers
Ashton's Classic Barbers

Eyelash Service
Stanton Optical Chesapeake

Beauty & Spas
Bondi Body

Medical Spas
Culture Aesthetics & Wellness - Kingston Pike

Cosmetics & Beauty Supply
Skin Tech Skin Care

Medical Spas